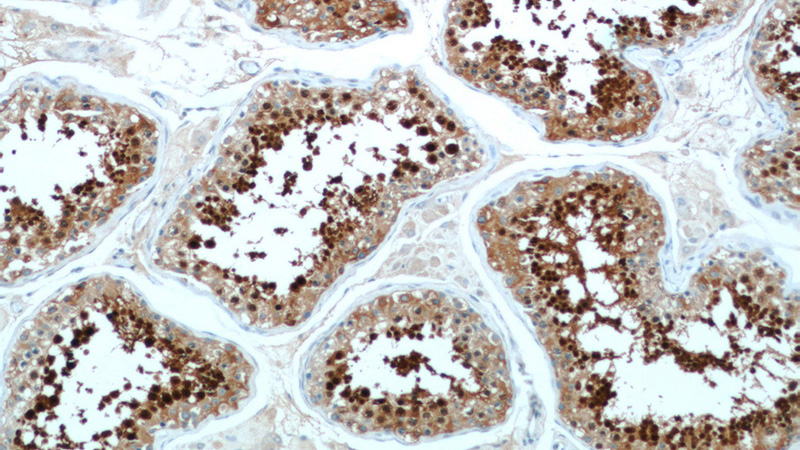
Immunohistochemical of paraffin-embedded human testis using Catalog No:111574(HSPA2 antibody) at dilution of 1:50 (under 10x lens)
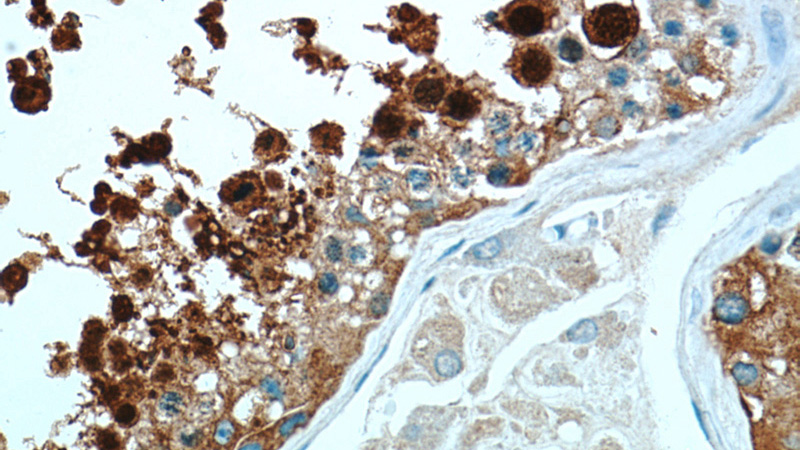
Immunohistochemical of paraffin-embedded human testis using Catalog No:111574(HSPA2 antibody) at dilution of 1:50 (under 40x lens)

-
Product Name
HSPA2 antibody
- Documents
-
Description
HSPA2 Rabbit Polyclonal antibody. Positive IHC detected in human testis tissue, human prostate hyperplasia tissue. Positive FC detected in HeLa cells. Positive IP detected in mouse skeletal muscle tissue. Positive WB detected in human ileum tissue, A431 cells, HeLa cells, human brain tissue, human kidney tissue, human skeletal muscle tissue, MCF7 cells. Observed molecular weight by Western-blot: 65-70 kDa
-
Tested applications
ELISA, WB, IHC, FC, IP
-
Species reactivity
Human,Mouse,Rat; other species not tested.
-
Alternative names
Heat shOCk 70 kDa protein 2 antibody; heat shOCk 70kDa protein 2 antibody; HSP70 2 antibody; HSP70 3 antibody; HSPA2 antibody
-
Isotype
Rabbit IgG
-
Preparation
This antibody was obtained by immunization of HSPA2 recombinant protein (Accession Number: NM_021979). Purification method: Antigen affinity purified.
-
Clonality
Polyclonal
-
Formulation
PBS with 0.1% sodium azide and 50% glycerol pH 7.3.
-
Storage instructions
Store at -20℃. DO NOT ALIQUOT
-
Applications
Recommended Dilution:
WB: 1:500-1:5000
IP: 1:500-1:5000
IHC: 1:20-1:200
-
Validations

human ileum tissue were subjected to SDS PAGE followed by western blot with Catalog No:111574(HSPA2 antibody) at dilution of 1:300
Immunohistochemical of paraffin-embedded human testis using Catalog No:111574(HSPA2 antibody) at dilution of 1:50 (under 10x lens)

1X10^6 HeLa cells were stained with 0.2ug HSPA2 antibody (Catalog No:111574, red) and control antibody (blue). Fixed with 90% MeOH blocked with 3% BSA (30 min). Alexa Fluor 488-congugated AffiniPure Goat Anti-Rabbit IgG(H+L) with dilution 1:1000.

IP Result of anti-HSPA2 (IP:Catalog No:111574, 4ug; Detection:Catalog No:111574 1:1000) with mouse skeletal muscle tissue lysate 4000ug.
Immunohistochemical of paraffin-embedded human testis using Catalog No:111574(HSPA2 antibody) at dilution of 1:50 (under 40x lens)
-
Background
Human HSPA2 is a member of the HSPA (HSP70) family of heat-shock proteins, encoded by the gene originally described as testis-specific. Recently, it has been reported that HSPA2 can be also expressed in human somatic tissues in a cell-type specific manner. HSPA2 is a cytosol/nuclear protein able to translocate between cytoplasm and nucleus. HSPA2 is involved in sperm maturity, function and fertility. Aberrant expression of HSPA2 in testes has been connected with male infertility. Recently, HSPA2 has attracted increased interest due to its possible involvement in carcinogenesis of non-testicular tissues. This antibody well recognized the endogenous HSPA4 protein in testis and multiple cell lines. (21373891)
-
References
- Sun F, Palmer K, Handel MA. Mutation of Eif4g3, encoding a eukaryotic translation initiation factor, causes male infertility and meiotic arrest of mouse spermatocytes. Development (Cambridge, England). 137(10):1699-707. 2010.
- Esakky P, Hansen DA, Drury AM, Moley KH. Molecular analysis of cell type-specific gene expression profile during mouse spermatogenesis by laser microdissection and qRT-PCR. Reproductive sciences (Thousand Oaks, Calif.). 20(3):238-52. 2013.
- Esakky P, Hansen DA, Drury AM, Moley KH. Cigarette smoke-induced cell cycle arrest in spermatocytes
Related Products / Services
Please note: All products are "FOR RESEARCH USE ONLY AND ARE NOT INTENDED FOR DIAGNOSTIC OR THERAPEUTIC USE"
